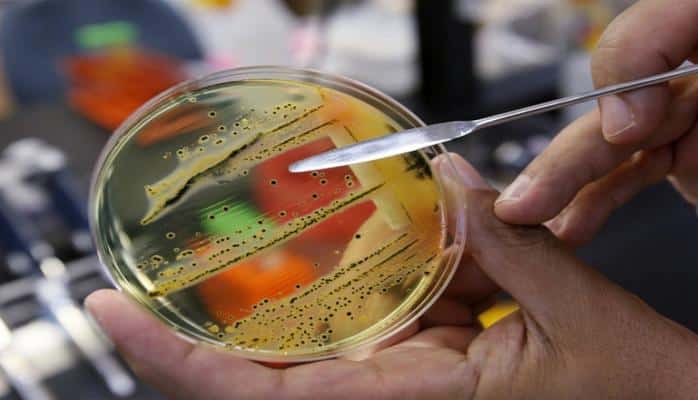

Dərc edildi: Baxış sayı: 1498
Yayın bəlası: Salmonellyoz- Kimlər necə yoluxur?
Hər il dünyada 150 milyon insanda salmonelyoz yoluxması qeydə alınır.
Onlardan 25.000 nəfəri bu xəstəliyin ağırlaşmasından ölür.
Salmonellyoz nədir, bağırsaqların qənimi olan infeksiyaya necə yoluxurlar?
Medicina.az salmonellyozun səbəb və əlamətlərini təqdim edir.
Bu infeksion xəstəlik salmonella adlı bakteriyalar tərəfindən törədilir. Digər bağırsaq infeksiyaları kimi, salmonella da çubuqvari formadadır. Bir salmonella ailəsində 2000dən çox bakteriya serotipi olur. Bakteriyaları dəfələrlə böyüdülmüş lupada elektron mikroskop altında görmək olur.
Bu bakteriya kifayət qədər davamlıdır, hətta aşağı temperaturda da dözür. Dondurulduqda çoxalması dayanır və onlar yatır, lakin ölmürlər.
Bakteriya o qədər "sırtıqdır” ki, buzxanada yarım il yaşaya bilər, çiy ətdə isə 4 ay ömrü olur.
Yer üzündə ən çox Asiya, Afrika, Cənubi Amerika kimi ölkələrdə, daha çox ət yeyən əhali arasında yayılır.
Yoluxma yolları:
-Xəstə adamdan
-Kontakt, toxunma
-Hematogen yolla
-Ərzaq məhsulları: toyuq, mal əti və s.
-Yumurta
-Süd, süd məhsulları
Salmonella bir çox quş növlərinin mədə-bağırsağında əbədi yaşayır. Quşlar, toyuqlar insandan fərqli olaraq infeksiyanın daşıyıcısı hesab edilir, onlar bu bakteriya ilə xəstə olmur.
Quşçuluq fabriklərində bu infeksiyalara qarşı dərman antibiotik müalicələri aparılır, amma bu da o demək deyil ki, broyler toyuqları salmonelladan təmizdir.
Yumurta infeksiyalı toyuqdan çıxan zaman yumurtanın qabığından bakteriya içinə daxil olur.
Ona görə yumurtanı yusam, salmonella olmayacaq fikri yanlışdır. Çünki bakteriya artıq yumurtanın içindədir.
Statistika görə, adətən 25.000 yumurtada bii salmonellozlu olur.
Ən təhlükəsiz yumurta bu baxımdan bildirçin yumurtasıdır.
Eləcə də xəstəliyi yumurta və pasterizə olunmamış süd istifadə olunmuş bütün qida məhsulları yarada bilər. Məsələn, yoqurtlar, kərə yağı, kremlər, xama, şirniyyatlar və s.
Nə toyuq, nə yumurta, nə ərzaq dadı, rəngi, qoxusuna, görünüşünə görə fərqlənmir, xəstə olması barədə şübhə yaratmır.
Yoluxmaq üçün elə həmin ərzağa toxunmaq, əlləri sürtmək, səthinə əl vurmaq kifayətdir.
Bir dəfə ABŞ-da 230.000 insan əvvəllər çiy yumurta daşınmış konteynerdə daşınan dondurmanı yeyərək salmonelloza yoluxmuşdu və həmin bölgədə infeksiya alovlanmışdı.
Xəstəliyin əlamətləri:
Orqanizmə infeksiya düşdükdən 3-6 saat sonra bakteriya çoxalmağa başlayaraq, intoksikasiya verir və əlamətlər üzə çıxır:
-Ürəkbulanma
-Baş ağrısı
-Halsızlıq
-Hərarət
-Qusma
-İshal
-Qarın ağrısı
-Tualetə tez-tez çağırış, orqanizmdən çox maye itkisi
-Susuzlaşmadan uşaqlarda qıcolma
-Əgər körpə və ya uşaq öz çəkisinin 10% qədərində maye itirsə, susuzlaşmadan ölə bilər
Müalicəsi
Mütləq susuzlaşmaya qarşı infuziya, bakteriyaya qarşı isə antibiotik təyin edilir.
Tam müalicə olunmayan insan infeksiya daşıyıcısı olur və real təhlükədir.
Daşıyıcı olan insanın öd kisəsində salmonella bekteriyası sanki məskən salır və gələcəkdə öddə onkoloji şiş yaradır.
Qorunma yolları
Ət, süd, yumurta kifayət qədər yaxşı, yüksək temperaturda bişirilməli. Xüsusən açıq bazarda satılan kənd məhsullarında bu təhlükə daha çoxdur. Çiy yumurta qəti olaraq qəbul etmək olmaz
Pasterizə olunmamış çiy süd 5 dəqiqə qaynadılmalıdır.
Ət, toyuq kəsilən taxta ilə tərəvəzlərinki ayrı olmalıdır.
Ət, toyuq, balıq əlcək taxılmış əllərlə kəsilməli, doğranmalıdır.
Mütləq qaynar su ilə bıçaqlar, taxta, qab-qacaq və mətbəx mebeli səthi yuyulmalıdır.

Şərhlər
Şərhləri göstər Şərhləri gizlət